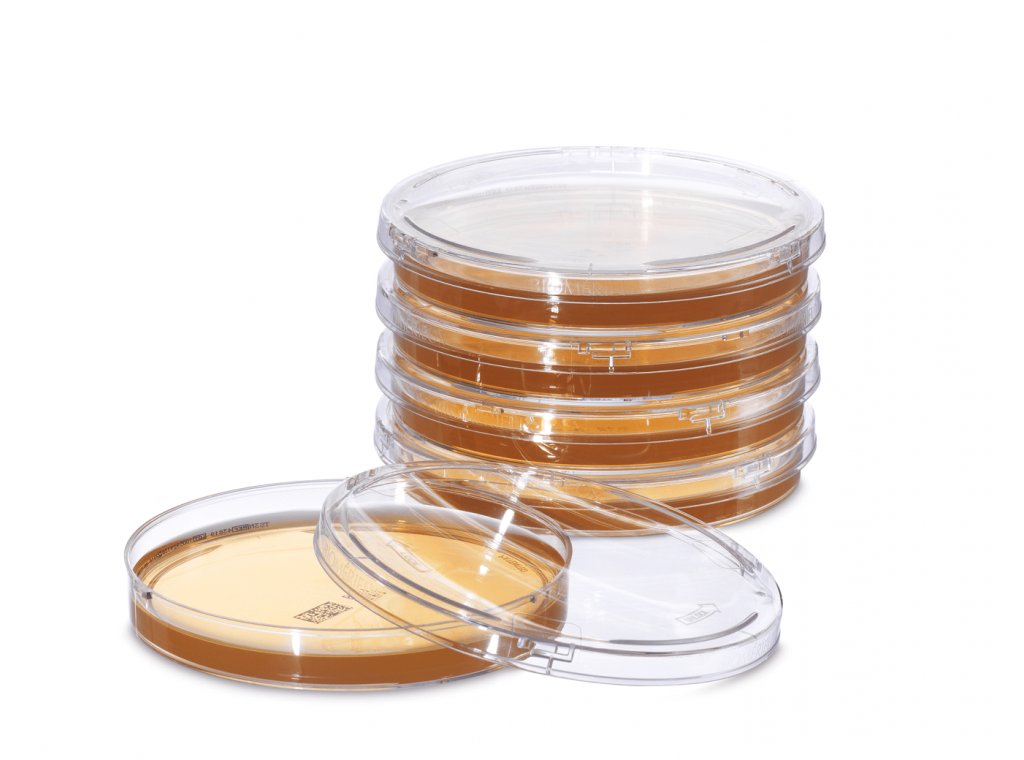

Empowering Innovation In Cell & Gene Therapy
Your innovative therapies require reliable testing systems that can deliver timely and precise results. In the high-stakes field of cell and gene therapy, there is no time to lose when a patient relies on your product - streamlined quality control testing is vital.
Do Your Cellular Therapies Have High Performance Quality Control?
Developing cell and gene therapies presents many challenges, including low production volumes, short shelf lives, temperature sensitivity, and complex raw materials. Addressing these issues requires meticulous attention to tracking and data integrity, scalability, and patient demands. Integrating rapid and user-friendly technologies into your operations is essential. These technologies streamline workflows, enhance manufacturing efficiencies, and provide accurate, actionable results that are crucial for maintaining patient safety.
Discover Our Proven Portfolio Of Value-Added Cell & Gene Therapy Solutions:
Download the Brochure
- Filename
- BROCHURE_CGT_ACCELLIX_A4_05_23_9324115-print.pdf
- Size
- 522 KB
- Format
- application/pdf
Cell & Gene Therapy Solutions
-
BACT/ALERT® 3D
The Method Of Choice For Rapid Sterility Testing
BACT/ALERT® 3D was developed as an effective and safe solution for industrial sterility testing. From its ease of use to its flexibility, BACT/ALERT® 3D is a state-of-the art microbial detection system suitable for any size laboratory, providing you with a reliable and objective alternative to traditional microbial detection methods.
-
BIOFIRE® Mycoplasma
1-Hour Mycoplasma Testing by Anyone, Anywhere, Anytime
BIOFIRE® Mycoplasma provides simple, accurate, and rapid in-house mycoplasma detection for use in testing raw materials, in-process samples, and final product release. We offer validation services designed to meet regulatory requirements—from documentation to comprehensive on-site support.
-
3P® ENTERPRISE
Em-power the Future
Bridging the gap between standard processes and automation, 3P® ENTERPRISE transforms the future of environmental monitoring in the pharmaceutical industry. From sampling to trending, take control with an end-to-end, fully digitalized and automated workflow. Increase efficiency and ensure your products are safe and compliant with an innovative environmental monitoring system.
-
SCANRDI® CELL-BURST
Same-shift sterility testing for cell & gene therapies
Removing sterility testing as a bottleneck, the CELL-BURST Solution completes the SCANRDI® system and provides an ultra-rapid method to enable earlier release and accelerate patient access to life-saving therapies.
-
VITEK® MS PRIME MALDI-TOF Mass Spectrometry System
Superior Workflow. Prime Results.
The VITEK® MS PRIME is an innovative MALDI-TOF mass spectrometry system that takes your automated identification experience to the next level.
-
BIOBALL® Standardized Strains
Microbiological Quality Control
BIOBALL® is a small water-soluble ball containing a precise number of microorganisms that delivers accuracy and precision, batch after batch.
-
3P® CONNECT SOFTWARE
Em-body Connectivity
3P® CONNECT is designed to secure sample traceability and collection of your Environmental Monitoring (EM) data to ensure reliable decision-making and optimize process efficiency. This comprehensive system includes dedicated software and performant pre-barcoded 3P® SMART PLATES. Skipping the traditional paper-based process for EM decreases risk of errors and saves time during the entire production process.
-
3P® Environmental Monitoring Culture Media
Bringing Confidence to Your Environmental Monitoring
Accurate and reliable environmental monitoring solutions will bring you confidence when making product release decisions, allowing you to protect your product and your patients.
-
3P® SMART PLATES
Em-brace Traceability
When conducting routine microbial surveillance of pharmaceutical manufacturing facilities, accuracy can empower you to make smarter decisions, meaning products, employees, and patients remain safe, and your business operates in compliance with regulatory guidelines. When it comes to Environmental Monitoring (EM), state-of-the-art culture media is a necessity when you’re counting on traceability and definitive results.
-
3P® Support & Services
Your Vision, Our Mission
As your partner, we’re committed to providing you with the assistance and services you need to make implementation easier and faster.
Contact Our Experts For More Information On Our Cell & Gene Therapy Solutions
Complete the form below to get in touch with our team. A bioMérieux expert will be in touch using the contact information you provide. By providing your information, you agree to receive additional emails from bioMérieux about microbiological quality control.
To find out more about the management of your personal data and to exercise your rights, see our privacy policy.